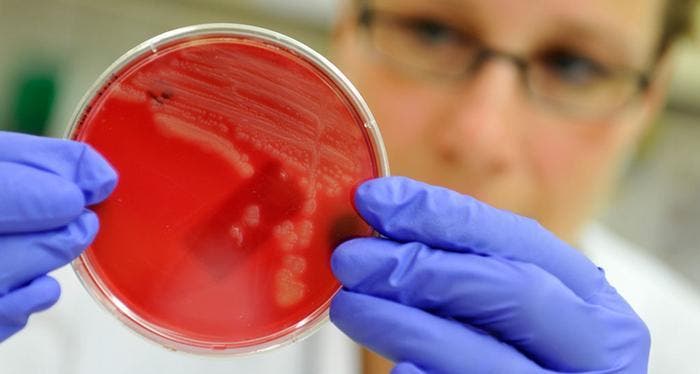

El fallecimiento de una mujer de Nevada (EE.UU.), en septiembre de 2016, a causa de un extraño virus, desató alarmas en la comunidad médica y científica. La víctima contrajo una enfermedad cuando fue ingresada en un hospital de la India cuando se fracturó una pierna en agosto de 2016.
Dicha fractura derivó en una infección de su cadera que los médicos intentaron tratar con todo tipo de antibióticos sin que ninguno diese resultado. La bacteria resistió todos los antibióticos existentes y legales que se le suministraron a la mujer a su regreso a EE.UU., incluso la colistina, una de las armas más potentes de la actualidad contra la resistencia de las bacterias que, junto al carbapenem, es empleada por los médicos como último recurso cuando todos los demás fallan.
Este caso es similar al de una peligrosa 'superbacteria' resistente a los antibióticos identificada en Corea del Sur el pasado mes de noviembre que presenta el gen MCR-1. Este gen, descubierto originalmente en China en 2015, resiste a los antibióticos más potentes, incluidos la colistina y el carbapenem, habiéndose detectado casos de este tipo en más de 20 países de todo el mundo, incluidos Estados Unidos y Europa.
En cualquier caso, lo más curioso y temible de la bacteria que acabó con la vida de la mujer estadounidense el pasado año es que ésta no portaba el gen MCR-1, por lo que aún no está claro cómo el germen adquirió tanta resistencia a los antibióticos, recoge un informe del Centro de Control y Prevención de Enfermedades de EE.UU. publicado este viernes.
Tags:

.png)
.png)




